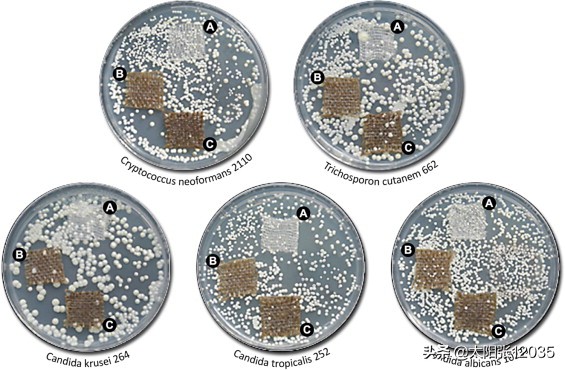
生物塑料纤维，学习翻译

生物塑料纤维
新的亚麻生产用于医疗目的的生物塑料纤维
作者 A. Kulma 一个b ÇK. Skórkowska-Telichowska dK. Kostyn 一个bM. Szatkowski 一个ÇJ. SKALA ËZ. Drulis-卡瓦ËM. 普瑞斯纳一个b ÇM. ZUK 一个b ÇĴ 。Szperlik 一个Y.F. Wang fJ. Szopa a b c
强调
•
转基因纤维含有与纤维素聚合物连接的聚羟基丁酸酯。
•
由转基因亚麻纤维制成的织物具有抗微生物特性。
•
由转基因亚麻织物制成的伤口敷料促进慢性溃疡的愈合。
抽象
亚麻(Linum usitatissimum)是一种栽培历史悠久,在医药和工业中具有重要意义的一年生植物。为了提高亚麻产品的宝贵品质,亚麻基因组已经过基因改造,其具体目标是改善亚麻特性和各行业的实用性。通过引入来自真养雷氏菌(Ralstonia eutropha)的多羟基丁酸酯(PHB)合成基因进入亚麻基因组后,纤维的生物力学性能得到了改善。在本文中,我们报道了除PHB外,这些纤维含有较高量的酚类,因此使改性纤维成为非常适合生物医学应用的材料,条件是织物不经过化学处理。亚麻PHB-织物促进人成纤维细胞增殖,并且已经显示在体外研究中具有抗微生物活性。基于这种织物的质量,开发了用于慢性伤口的新敷料,并证明其在临床前试验中是成功的。因此,证明改性亚麻纤维是生物医学工业的合适材料关键词
亚麻纤维
抗氧化剂
聚羟基丁酸酯
慢性伤口愈合
1 。介绍
几个世纪以来,来自不同物种的天然纤维已被人类社会用于许多应用。由于其产品,纤维和种子,亚麻通常被认为是两用植物,是这种植物之一。纤维,作为原料用于纱线的生产,用作一个主要来源以制造纺织品服装和在复合生产(建筑或 汽车行业)(Bledzki等人,2008年,Powell等人,2002),而种子压提取食用油。总的来说,韧皮亚麻纤维构成不同多糖的复合物 聚合物,如纤维素,半纤维素和果胶,以及木质素的酚类聚合物(Fincher,2009,Weng等,2008)。这些聚合物的量,它们之间的比例,单体组成,取决于许多因素,并且在物种,器官,组织和细胞类型之间变化(McDougall,1993)。纤维素覆盖纤维重量的约70%,而半纤维素占约15%。其余为木质素(2-5%),果胶(1-15%),酚酸(0.1%),蜡和无机化合物(2-5%)(Gorshkova等,1996, Morvan等,2003)。
纤维素是β-1,4-葡萄糖的无支链生物聚合物,并且以两种构象存在,无定形和结晶,其决定了纤维的物理性质。结晶纤维素越少,吸水性越好(Bos等,2002, Stamboulis等,1999)。游离

OH基团的数量与纤维素的亲水特性相关( Bledzki等,2008 )。果胶是一种糖聚合物,主要由半乳糖醛酸骨架聚合物构成,其通过 α-1,4-糖苷键与各种糖分支( Baley等,2012)。半纤维素与纤维素强烈结合通过许多氢键。除

OH基团外,半纤维素含有许多乙酰基,使其部分溶于水并具有吸湿性。纤维素 - 半纤维素结构由木质素增强,木质素与半纤维素共价键合。木质素纤维成分在苯丙烷类通路内合成,是一种纤维酚类物质。亚麻中苯丙烷途径的存在和功能确保存在与木质素及其前体不同的其他亚麻中的苯丙烷类化合物。它们是广泛且重要的次级代谢物组,参与植物生长,发育和植物防御对抗病原体( Cushnie和Lamb,2005, Lattanzio等,2006, Winkel-Shirley,2001)。亚麻纤维与其他天然纤维的区别在于,由于苯丙烷类化合物,它们具有生物活性。
近几十年来,对亚麻遗传学的研究迅速发展,为科学家和育种者提供了改善植物/纤维质量生产的工具( Cobb等,2013,Moose和Mumm,2008,Wang等,2013 )。现代植物生物技术中最受开发的方法是为科学和商业目的生成转基因生物。应用基因工程的基础研究和应用亚麻育种的研究成为可能,是因为基因技术和转化技术已得到改进。预计更好地理解涉及纤维生产力,质量和新特性的基因将通过基因工程方法提供纤维质量改进的目标,从而导致衍生自亚麻纤维的更多样化的产品。对于纺织品或复合材料应用而言,有关细胞壁发育的改进知识可能有助于产生具有更好品质(更长,更薄,柔软,有弹性等)的新型植物纤维。此外,植物细胞壁中的修饰将允许获得易于提取的纤维。这些修饰之一可以是引入聚羟基丁酸酯(PHB)合成基因进入亚麻基因组。我们先前已经产生了携带来自真养罗尔斯通氏菌的三种细菌基因的转基因亚麻植物,其编码PHB 生物合成 酶。来自14-3-3基因的16R同种型的茎/纤维特异性启动子(Aksamit等,2005)和用于转变为质体的Rubisco 基因序列已被使用。植物显示出不变的表型和合理的PHB量的产生( Wróbel等,2004)。这种改性还导致纤维具有大大改善的生物力学性能,其中PHB在植物生长期间通过氢键和酯键与纤维聚合物中的纤维素结合。以前,这些纤维成功地用于复合材料的制备(Szopa等,2009 ),聚丙烯和聚丙交酯基质,成功地用作组织工程支架( Gredes等,2010 )。通过GS-MS对体外生长的植物进行的代谢组学分析表明,遗传修饰导致苯丙烷类水平的改变(Wróbel等,2004)。
在本研究中,更详细地研究亚麻纤维的酚含量以确定改性对苯丙烷代谢的影响并确定来自PHB过表达植物的亚麻产品用于生物医学应用,特别是伤口敷料生产的有用性。慢性非愈合性溃疡是临床实践中的关键问题,并且是现代医学的主要挑战之一。慢性伤口发病机理中的一个问题是与活性氧物质相关的伤口床中的细胞增殖不良和细胞增殖的抑制。在这方面,PHB特别令人感兴趣,因为它与体液接触时会降解释放 d, l-β-羟基丁酸酯促进高密度培养物中细胞的增殖,从而防止凋亡细胞死亡(Cheng等,2006,Ji等,2008)。这是关于成功使用PHB纤维素复合纤维伤口敷料治愈人类慢性静脉病因伤口的第一份报告。
2 。材料和方法
2.1 。植物材料和生长条件
亚麻(var.Nike)种子由波兰天然纤维研究所(波兰波兹南)提供。使种子萌发并在以下条件下在温室中生长: 在21 ℃下在光照下16小时, 在16 ℃在黑暗中 8小时。使植物在土壤(分开的盆,每天浇水)和补充有蔗糖(1%)和琼脂(0.8%)的 Murashige和Skoog(MS)培养基(Murashige和Skoog,1962 )中生长。从土壤培养的培养物中获得的种子用于亚麻植物的田间培养,其进一步用作织物纤维的来源 生产。
2.2 。转基因植物的构建和选择
携带来自富养罗尔斯通氏菌的三种PHB合成基因的转基因亚麻M型植物如前所述产生和选择(Wróbel等,2004)。
2.3 。亚麻ret制
所有转基因植物都生长在弗罗茨瓦夫附近的田地中,并在4个月后收获。收集的植物通过在田地中展开6周来进行ret制,每14天转动一次秸秆。这被称为"露水法",其中微生物 在ret制期间消化植物细胞壁多糖(Henriksson等,1997)。
2.4 。红外光谱
红外(IR)光谱检测和记录在400-4000范围 厘米-1(具有2分辨率 厘米-1 )用FT-IR的Biorad 575C 分光计(美国)。用溴化钾 颗粒和Nujol悬浮液制备每个样品。该过程在室温(20 ℃)下进行。
2.5 。纤维素水平分析
使用比色法(Updegraff,1969 ) 测定来自对照和转基因植物的纤维中的纤维素含量。第一步是去除木质素,半纤维素和xylosans孵育用混合物硝酸和乙酸(1:8,V / V,30分钟,100 ℃)和离心。用纯水洗涤两次后,将得到的沉淀物悬浮在1ml 67%(v / v)硫酸中。用蒽酮试剂将样品稀释10倍,并在100 ℃ 下温育15分钟。在620处通过分光光度法测量纤维素水平 nm用蒽酮试剂作为空白。
2.6 。木质素水平分析
为了确定纤维中木质素的含量,使用乙酰溴法(Iiyama和Wallis,1990)。纤维样品得自田间生长的亚麻。将干燥的纤维倒入 10ml水中并在65 ℃ 下孵育1 小时,每10 分钟搅拌一次。在下一步骤中,将样品通过GF / A 玻璃纤维过滤器过滤并用四种溶剂洗涤:水,乙醇,*酮丙**和*醚乙**。将滤膜在玻璃小瓶中于70 ℃ 温育 12 小时。然后,将滤膜在50 ℃下与2.5ml 25%乙酰溴一起温育2 小时,冷却后与10ml 2 混合。 M NaOH和 12ml乙酸。第二天,在280nm 处用分光光度法分析样品,用松柏醇制备校准曲线。结果表示为松柏醇当量。
2.7 。果胶水平分析
Melton和Smith(2001)描述的方法的改进用于测定纤维中的果胶水平。首先,将样品用96%乙醇在100 ℃ 洗涤并离心。然后,将沉淀物用80%乙醇在80 ℃处理,随后用氯仿和甲醇(1:1,v / v)的混合物洗涤,然后用*酮丙**洗涤。将得到的颗粒在37 ℃下干燥,冷冻并称重。总的水平果胶在酸性水解后,测定(100微升水中2 SO 4每5 毫克的粒料的)。然后,分三步(50μl,150μl 和700)加入900μl 蒸馏水 μl)各自然后搅拌(5 分钟,4 ℃)。用分光光度法在520nm测定果胶水平,用半乳糖醛酸制备校准曲线。
2.8 。酚类成分提取
为了从纤维或织物中提取酚类化合物,使用了Subba Rao和Muralikrishna描述的改进方法(Subba Rao和Muralikrishna,2002)。 使用Retsch研磨机研磨每个样品(1g)并用甲醇萃取三次。合并级分,真空蒸发,并重悬于1ml甲醇中。甲醇后的剩余物萃取被用于分析细胞壁约束的酚组分。将沉淀物用 2M NaOH在37 ℃ 水解。24 小时后,弃去沉淀,将上清液的pH调节至3. 用乙酸乙酯萃取溶液 合并三次,将有机溶剂真空干燥。将剩余物重新悬浮在 1ml甲醇中并用于进一步分析。
2.9 。总酚含量的估算
为了确定总游离和酯结合酚的含量,使用Folin-Ciocalteu方法(Gómez-Alonso等,2002)。向等份的提取物中加入稀释的Folin-Ciocalteu试剂。然后,向每个样品中加入饱和碳酸钠和水。在725nm 处通过分光光度法测量总酚含量。结果表示为没食子酸当量。
2.10 。酚醛树脂的UPLC分析
使用BEH C18,2.1亚麻织物提取物进行分析 毫米 × 100 毫米,1.7 配备有2996 PDA的Waters ACQUITY UPLC系统上μm柱检测器和QTOF质量检测器。流动相为A = *腈乙**/ B = 0.1%甲酸,梯度流速:1 分钟 - 95%A和5%B,2-12 分钟 - 梯度至70%A和30%B,12-15 分钟 -梯度为0%A和100%B,15-17 分钟 - 梯度至95%A和5%B,流速为0.4 ml / min。的质谱是在ESI +模式下采集17在50-800的范围内分钟沓,根据以下参数:氮气流800 升/小时,源温度70 °C,去溶剂化温度锥体400 °C,毛细管电压3.50,采样锥30,锥形电压斜坡40-60 V,扫描时间0.2 s。根据保留时间,紫外光谱以及标准化合物的质谱确定组分。
2.11 。PHB测定
用0.5 升氯仿萃取纤维(30 克)。在真空干燥溶剂后,使用浓H 2 SO 4 在90 ℃下将提取的PHB水解30 分钟。将样品稀释50倍和使用BEH C18,2.1分析 毫米 × 100 毫米,1.7 配备有2996 PDA检测器和QTOF质量检测器的Waters ACQUITY UPLC系统上毫米柱。流动相为A = *腈乙**/ B = 0.1%甲酸,梯度流速:1 分钟,1%/ 99%A / B,2-5 分钟梯度至40%/ 60%A / B,和6-7 最小梯度为40%至100%A, 流速为0.4 ml / min。
2.12 。抗氧化潜力的测定
将6μl 研究的植物提取物的等分试样与 200μlDPPH试剂(1,1-二苯基-2-苦基肼基)混合。将样品在室温下在黑暗中温育15 分钟,然后在515nm 处测量吸光度。对照样品是1ml DPPH和6μl甲醇。空白样品是纯甲醇。抗氧化性能表示为抗氧化潜力(等于以百分比表示的自由基反应的抑制)(Brand-Williams等,1995)。
2.13 。疏水成分的提取
使用Retsch研磨机研磨织物并用氯仿萃取三次,干燥溶剂并将剩余物重新悬浮在 100μl甲醇中。在通过 0.25μmAcrodisc 过滤后,将提取物用于进一步分析。
2.14 。UPLC分析疏水成分
用装有使用BEH C18柱(2.1光电二极管阵列检测器的Waters ACQUITY UPLC系统执行疏水性成分分析 毫米 × 150 毫米,1.7 微米的颗粒)加热至40 ℃。流动相为A:*腈乙**,B:梯度流动的水。1 分钟70%A / 30%B,2-5 分钟梯度至100%A / 0%B持续接下来的5 分钟和10-11 分钟梯度至70%A / 30%B持续至第12 分钟。流速为0.4 毫升/分钟。将三氟乙酸(0.05%)加入到A和B溶剂中以防止拖尾。光电二极管阵列检测器(PDA)用于测量210-500nm范围内的吸收。对*麻大**二酚进行峰的检测和整合 (CBD)在230nm 处,而叶黄素在445nm 处。
2.15 。织物准备
该纱线受到了两个方面准备。第一种方法采用传统和工业处理方法,包括用各种化学品煮沸和漂白的几个步骤,包括碱(NaOH)处理,产生白色软纱。第二种是基于随后用于织物生产的化学未加工纱线。该织物经过翻滚过程,类似于纺织工业使用的过程。通过该方法获得的织物具有天然纤维颜色(灰色)并且令人满意地柔软(类似于通过传统方法获得的柔软度)。对于两种织物的生产,使用标准编织方法进行织物制备。经线和纬线的密度分别为65 / dm和85 / dm,线性质量为140TEX。最终亚麻织物的密度为220g / m2。
2.16 。细菌菌株
12种临床菌株:金黄色葡萄球菌(n = 4),表皮葡萄球菌(n = 4)和粪肠球菌(n = 4)用于测定来自转基因亚麻的转基因织物的抗菌活性。将金黄色葡萄球菌从ATCC 6538株美国典型培养物保藏用作参考。将细菌在-70 ℃下储存在Trypticase Soy Broth中,加入20%甘油直至进一步使用。
2.17 。由转基因纤维制成的织物的抗菌活性的测定
通过测定转基因织物对细菌生长的影响,将其与棉花和非转基因织物的抗菌活性进行比较。通过根据ISO / DIS 20645:2004标准的方法(http://www.iso.org/iso/home/store/catalogue_tc/catalogue_detail.htm?csnumber=35499 ) 测试抗微生物活性。将灭菌的样品置于双层琼脂平板上。将细菌菌株接种到琼脂平板的上层上,并在37 ℃ 下孵育 18 小时。然后通过检查样品和琼脂表面之间的接触区中细菌生长的抑制来确定测试织物的抗微生物活性水平。每次测定 一式三份完成。
2.18 。病原真菌菌株
致病的六个临床株真菌用于测定从遗传修饰的亚麻纤维制成的织物的转基因的抗真菌活性:克柔念珠菌 153,克柔念珠菌 264,新型隐球菌 2110,丝孢cutanem 662,热带假丝酵母 252,白色念珠菌 10231.这些菌株从获得的大学弗罗茨瓦夫微生物研究所收集,波兰。
2.19 。由转基因纤维制成的织物的抗真菌活性的测定
将在YPD培养基上预培养的真菌稀释并涂布在YPD琼脂平板上,并将测试的织物置于琼脂表面上。或者,将接种物重新悬浮在含有琼脂的培养基中,倒在平板上,并在固化之前将一块织物包埋在培养基中。将板在37 ℃ 下孵育 24 小时,然后计数表面上的真菌菌落和"深度生长"(嵌入的织物)。
2.20 。通过MTT试验测定成纤维细胞活力
正常人类皮肤成纤维细胞(NHDF)(Lonza公司,瑞士)细胞接种在24孔板中,每孔含有1.5 50,000个细胞在DMEM培养基(Lonza,Switzerland)中生长 克/升葡萄糖,10%胎牛血清,100 U / ml的青霉素和100μg/ ml 链霉素并留下过夜粘合。将所述培养基用一整天后,新鲜的一个,和0.5替换厘米2个亚麻织物的片段(由灭菌高压灭菌预先)放入孔中。未处理的细胞构成对照。将板孵育24小时 H。此后,在每个孔中加入MTT(溴化3-(4,5-二甲基噻唑-2-基)-2,5-二苯基四唑)(Sigma,USA)溶液,终浓度为0.25mg / ml。将板孵育4 小时并弃去培养基并用500μlDMSO代替以溶解甲crystals晶体并在工作台上放置30分钟。随后,使用Asys UVM340微板读数器(Biochrom,UK)在570nm 下记录所得溶液的吸光度值。MTT测定进行三次以确保结果的可重复性,其以对照的百分比表示(100%)。
2.21 。临床前试验
2.21.1 。亚麻敷料的制备
通过在120 ℃ 下高压灭菌20 分钟来对亚麻织物进行灭菌。该织物用于伤口治疗的尺寸为10 厘米 × 10 厘米 每片织物在使用前用0.9%NaCl溶液浸泡。
2.21.2 。耐心
该研究组由患有慢性不愈合的静脉溃疡的患者组成。患者在波兰弗罗茨瓦夫Ars Medica诊所的皮肤科门诊就诊。该研究获得了独立生物伦理委员会的批准。所有患者都被告知研究的目的和过程。伤口全部位于患者的腿上。22名患者(11名女性,11名男性,平均 年龄 65 ± 使用由M纤维制备的敷料为伤口愈合提供了8年的治疗。亚麻织物的处理针对患者,其局部和一般治疗既没有导致愈合也没有任何抑制溃疡的进展。该研究仅包括伤口持续至少12个月的患者。据报道,伤口床中没有宏观和微观细菌感染的病例。
2.21.3 。病人治疗
首先检查参与该研究的所有患者以评估他们的一般健康状况并排除可能影响结果的内部疾病的存在。指导患者每天如何更换亚麻敷料。治疗持续了四周,在此期间,医生检查了伤口,测量了他们的面积,并对患者进行了四次采访。第一个亚麻敷料由护士施用。
2.21.4 。测量伤口大小
伤口使用固定焦点拍摄的长度透镜,以确保的视图和规模的相同点。为了获得正确的刻度指示器,将市售的工业照相颜色标准表与伤口一起拍照。它既用于设置正确的图像颜色,也用于测量伤口。当伤口太大而不适合单个图像时,在伤口周围拍摄几个单独的图像以获得良好的伤口表面测量视图。通过计数伤口边界内的像素,使用照相软件进行伤口测量。作为参考,使用每 1cm 2 的像素数。1 厘米 2为每张图片拍摄了广场。如果伤口非常大以适合单张图片,则将连续图片中的所有片段相加。
2.22 。统计分析
学生t检验用于结果的统计分析。使用Statistica 7软件(Statsoft,USA)进行分析。
3 。结果
3.1 。纤维成分的分析
在田间生长四个月后,收获亚麻植物,然后在碾压后,将纤维从茎中释放出来并在工业上加工成纱线和其他织物。由于化学成分决定了纤维的质量及其对各种应用的适用性( Morrison Iii等,2000,Morrison和Archibald,1998 ),通过标准ret制工艺获得的纤维被分析并与从非转基因获得的纤维进行比较。植物。聚合物的水平(纤维素,果胶,测量亚麻纤维中的酚类成分,并将数据列于表1中。M纤维与其对照对应物的不同之处在于具有PHB聚合物和增加的可溶性酚类物质(对照的123%)和酯结合的酚类物质(对照的116.7%)。转化为巴豆酸后估计的PHB水平为 每 1g纤维51μg,证实了先前在体外培养中获得的植物的结果(Wróbel等,2004 )。由于酚类化合物是强抗氧化剂,它们的增加水平有望用于M纤维的生物医学应用。关于纤维成分及其数量的知识主要来自化学方法。尽管该方法产生令人满意的结果,但它具有破坏性并且不提供关于这些成分的空间排列的任何信息。IR 光谱作为非侵入性方法先前已用于在分子水平上表征亚麻纤维。分析特定的振动光谱带并将其与纤维素,果胶和木质素的特定*能官**团相关联。组分波数没有差异,但对照和M纤维的条带强度存在差异。M纤维中轮廓强度的增加表明纤维素的结晶结构更高( Szopa等,2009)。
表1。来自对照和转基因M系的纤维的化学组成。所呈现的数据是三次重复 ± 标准偏差的平均值。
PHB - polyhydroxybutyrata。结果在p < 0.05时具有统计学显着性。
3.2 。织物准备
来自转基因植物和对照植物的纤维的生物化学性质的比较表明M纤维应该是用于伤口敷料生产的合适材料。传统上,为了获得柔软的白色织物,使用化学和物理处理。事实证明,工业处理使木质素含量显着降低30%以上(42.28 ± 0.4至29.1 ± 0.6μg / mg DW),酚类衍生物降低20%以上(从1.85 ± 0.11至1.26 ± 0.08μg / mg DW) )。此外,成纤维细胞与加工(漂白)织物的孵育导致细胞立即死亡(图1 )。因此,对于生物医学应用,开发了用于织物制备的新技术。然后分析获得的纺织品(标记的未加工的M)的生物聚合物(纤维素,果胶,木质素)含量,抗氧化/抗炎成分和织物生物效应,并将结果与传统加工的织物进行比较。与化学加工的M转基因织物以及未加工的非转基因对照织物相比,未加工的M织物证明对培养的成纤维细胞没有细胞毒性。注意到化学处理的织物导致成纤维细胞活力的显着降低因此它毒性很大。观察到未处理的中号织物,这引起了增加的增殖相反的效果的细胞。在 孵育 24小时后,与对照(未处理的成纤维细胞)相比,细胞数高出36%(图1)。经过较长的孵育时间(48 小时,72 小时)后,观察到类似的结果。

图1。的影响织物处理对细胞存活力。(A) 在由加工和未加工的M转基因亚麻纤维和未加工的非转基因对照亚麻纤维制成的织物存在下培养24小时的成纤维细胞的活力测试。对照(100%)是在没有织物的情况下生长的成纤维细胞获得的值。结果在p < 0.05时具有统计学显着性。(B)人正常成纤维细胞(对照)的显微镜图像,并使用标准工业程序(加工的M)制备的织物和使用新方法获得的织物(未加工的M)孵育24小时。
3.3 。织物中的抗氧化成分
为了确定亚麻织物中主要酚类组分的特性,进行了甲醇可萃取(游离酚类)和NaOH释放(结合酚类)组分的UPLC分析。来自亚麻织物的甲醇提取物中很少有酚类衍生物,可以在UPLC分析中测定。游离酚类物质中最丰富的组分是非常亲水的组分,在308nm 处具有最大吸收(数据未显示)。该组分的光谱与p相同 - 富马酸,但保留时间表明它是酸的更亲水(也许是低聚糖)衍生物。与对照纤维相比,M转基因纤维中的组分含量更高。其他成分,如香草醛,阿魏酸和香豆酸,以有限的量存在(数据未显示)。随后将甲醇萃取的织物在 2M NaOH中水解,以释放酯化的酚类(Lozovaya等,1999 )。NaOH 水解产物的UPLC-MS分析显示存在几种组分:4-羟基苯甲酸,香草酸,香草醛, p- 香豆酸,丁香醛,乙酰香草酮和阿魏酸,但是其中一些成分的浓度非常低(表2)。
表2。用UPLC方法测定由对照和转基因M亚麻制成的织物中的化合物。所呈现的数据是三次重复 ± 标准偏差的平均值。
4-羟基苯甲酸(HBE),香草酸(VA),香草醛(VE),对香豆酸(COU),丁香醛(SYE),阿魏酸(FE),*麻大**二酚(CAL)和叶黄素(LU)。
*
统计学显着性,p < 0.05。
由转基因亚麻纤维产生的织物含有较高含量的测定化合物。发现香草醛含量是亚麻织物中最丰富的酚类。它 在转基因织物M中达到接近60μg/ g,并且与对照相比高出10%以上。对于丁香醛,观察到与对照相比最高的增加(超过15%)。转基因织物中的总酚类化合物含量比对照高10%。
在我们最近的工作中,我们在亚麻织物中发现了两种疏水性萜类化合物成分,数量合理。首先是叶黄素,一种强亲脂性抗氧化剂,属于类胡萝卜素家族,可能有助于亚麻纤维的抗炎特性(Styrczewska等,2013 )。该组分存在于所有亚麻织物中,然而,通过UPLC分析测定,与对照相比,其在M纤维中的水平高度提高。基于质谱分析,紫外光谱和UPLC中的保留时间的第二和新组分被鉴定为萜烯酚组分--CBD。进一步体外分析亚麻CBD对人体的影响成纤维细胞显示出其抗炎特性(Styrczewska等,2012)。发现该化合物存在于所有测试的织物中。CBD水平在M纤维中略微升高。
织物中苯丙烷类和类异戊二烯衍生物的存在强烈暗示其抗氧化潜力。因此,使用DPPH作为稳定的自由基,将织物提取物用于抗氧化性质测定。观察到与对照(43.17%)相比,来自转基因M系的织物显示出更高的自由基猝灭百分比(47.83%)。
3.4 。抗菌活性
3.4.1 。抗菌活性
测试由对照和M纤维制备的亚麻织物的抗菌活性,因为临床实践中的主要问题之一是伤口感染。在这种情况下,优选显示抗微生物活性或至少不促进微生物生长的材料。针对12种临床细菌菌株(金黄色葡萄球菌,表皮葡萄球菌和粪肠球菌)测试M织物。为了比较,在该实验中包括几乎纯的纤维素棉织物。结果可以在表3中找到。M和对照织物之间的主要差异是金黄色葡萄球菌的生长速率的差异隔离。与对照相比,观察到M织物具有更高的抗菌活性。表皮葡萄球菌的临床菌株对两种亚麻织物都敏感,除了表皮葡萄球菌1,其对所有测试材料都具有抗性。两种测试织物均未显示出对粪肠球菌的抑制作用。所有织物样品仅在接触表面上抑制细菌的生长。
表3。通过由非转基因对照和转基因M亚麻制成的织物抑制细菌生长; "+"正常生长," - "抑制。
3.4.2 。抗真菌活动
使用几种致病真菌的临床菌株测试亚麻织物的抗真菌特性。三种不同的方法被用于-当织物片段加入到在液体介质中测试培养基并在两个测试琼脂一个具有放置在表面上的织物,而另一个具有嵌入在介质中织物-固化的板。当在液体培养基中测定时未检测到织物的抗真菌活性(数据未显示),然而,观察到亚麻织物上真菌生长的表面抑制。图2显示了棉花上的真菌生长(包括在实验中用于比较)以及非转基因亚麻和转基因织物。可以清楚地看到,真菌菌落很容易在棉花表面形成,同时在亚麻织物上几乎看不到真菌生长。两种亚麻织物(对照和M型)之间没有观察到主要差异。然而,由于酵母菌落在平板上的不均匀分布,这种测试难以评估。由于这个原因,重复试验,将织物包埋在琼脂固化的培养基中,在倒入培养板之前加入真菌接种物。在该测试中,在许多深度生长的菌落中观察到差异。深层集落的数量在面积上明显较小在织物上,而且由转基因亚麻制成的织物显示出更高的抑制程度(表4)。转基因M织物对新型隐球菌最有效。通常,经测试的亚麻织物显示出有希望的抗真菌性质。它可以推测,抗微生物组分的含量是在一个织物相当低,因此它们在大的稀释体积的液体培养基中,但是这些化合物以足够的量被释放到周围区域,以抑制真菌生长在紧密接近。
. *载下**全尺寸图片
图2。表面抑制真菌菌落在棉织物(A),亚麻织物 -M型(B)和对照(C)上的生长。
表4。对照和转基因M亚麻织物嵌入病原真菌生长培养基中的影响。"+"的数量表示真菌生长的强度," - "完全抑制,完全缺乏菌落。
3.5 。慢性伤口治疗 - 临床前试验
由于观察到对细胞增殖的积极作用并且对培养的成纤维细胞没有细胞毒性(图1 )并且对动物的过敏试验证明是阴性的(数据未显示),来自转基因M纤维的织物可用于伤口敷料制备和测试。耐心。为了描述亚麻敷料处理后伤口的变化,考虑具有最客观特征的单个参数,这是伤口大小。
处理四周后,伤口尺寸显着减小(图3A),并且尺寸的平均减小为28%( 6cm 2 )。的统计分析(Ť试验相依样本)显示的M敷料在降低创伤大小比棉敷料具有统计学显着性(更有效的p < 0.001)。图3B显示了在M敷料的作用下伤口愈合过程的实例。经过一周的治疗后,出现了明显的表皮。伤口渗出水平降低,患者报告疼痛感降低 在M敷料使用期间。

图3。M敷料治疗后伤口大小变化的百分比。在22名患者中的1名(图中的黑色)中,观察到溃疡尺寸的增加。在一种情况下,观察到伤口的完全瘢痕形成(~100%)(A)。用M敷料进行慢性皮肤伤口治疗的例子。放大显示仅在治疗一周后(B),纤维蛋白减少,肉芽增强和新皮肤组织(轮廓白色)积聚。
4 。讨论
自农业开始以来,育种者选择具有最佳性质的植物,同时考虑到它们对人类需求的适应性。在亚麻育种中,这些修饰包括增加的病原体抗性,油质量和亚麻纤维的改善的性质。近年来,采用生物技术方法使亚麻纤维适应医药用途。第一个策略是通过同时表达三个矮牵牛基因(W92 植物)来产生过量产生黄酮类化合物的亚麻植物(Lorenc-Kukula等,2005, Styrczewska等,2012) )。随后,将来自这些植物的纤维用于伤口敷料,其被测试用于慢性皮肤溃疡的愈合。其次,这些纤维用作抗微生物组分的来源(Czemplik等,2011,Skorkowska-Telichowska等,2010 )。最近,生产PHB的新型亚麻纤维引起了极大的兴趣。与体液接触时的聚羟基丁酸酯降解为d,l -β-羟基丁酸酯的单体。单体可以防止高密度培养物中的细胞凋亡(Cheng et al。,2006 ),因此它们在大量再生的应用中提供了完美的解决方案。细胞是必需的。聚羟基丁酸酯本身已被用于生产外科手术工具(针,缝线,钉),组织工程(血管置换,骨替换和板,植入物,心血管补片或神经袖带)( Misra等,2006, Stojkovic等) al。,2013 ),以及作为药物输送系统中的微载体(Shrivastav等,2013 )。最近发现PHB单体通过阻止细胞死亡激活全球细胞转录(抑制组蛋白脱乙酰酶I类)和细胞增殖在高密度培养中,这种可生物降解的聚合物对慢性伤口愈合治疗具有吸引力( Cheng等,2006,Ji等,2008)。嵌入聚乳酸基质中的那些含有PHB的亚麻纤维成功地用作大鼠中的组织工程支架(Gredes等人,2010)。经测试的生物复合材料在皮下插入后未显示任何炎症反应,并显示出与肌肉组织的良好生物相容性。特别是血管内皮生长因子的mRNA表达与使用未改性纤维制成的复合材料相比,使用PHB复合材料时没有改变。因此得出结论,从产生"生物塑料"纤维的植物引入新的亚麻绷带可以引起细胞增殖的诱导,这在愈合过程中是至关重要的。当面料测试从产生PHB的植物产生的它们对伤口愈合的适应性,检测到伤口大小的显着减少。用M敷料处理后,减少覆盖了96%的受试者,比先前测试的W92织物多35%。仅在一种情况下,当用M织物处理时伤口的尺寸非常轻微(1.5%)增加,与W92敷料相比,这也是更好的结果,其中9名受试者在该参数方面显示出增加或没有变化( Skorkowska-Telichowska等,2010)。因此,建议含有PHB和增加水平的苯丙烷类化合物的织物在伤口处理中比改性的富含类黄酮的亚麻籽纤维具有更高的效力。
这些性质可归因于PHB含量与M纤维中酚类衍生物含量的增加。已知酚类是抗氧化剂,抗炎剂和抗微生物剂,因此它们改善亚麻纤维的生物活性功能。首先,它们清除氧自由基,这些自由基参与慢性伤口发病机制并阻碍愈合过程。氧化应激导致许多细胞机制的阻碍并导致成纤维细胞凋亡( Wlaschek和Scharffetter-Kochanek,2005 )。而且,酚类化合物充当金属离子的螯合剂,从而阻碍它们在自由基生成中的作用。此外,由于酚类物质调节氧化剂的水平,并影响后者介导的细胞信号转导(通过NFκB 调节细胞因子和趋化因子导致炎症反应的调节)( Amaral等,2009, Gomes等,2008), Rahman等,2006)。据报道,来自苯丙烷途径的低分子抗氧化剂促进了长期伤口的愈合( Angerhofer和Giacomoni,2008, Chiang等,2005, Phan等,2001)。)。酚醛含量的增加以及PHB的存在使新型亚麻纤维成为伤口敷料生产的优质材料。然而,如图所示,纤维和织物生产的典型工业加工去除了酚类成分,甚至使产品对人体细胞有毒。因此,在医疗器械生产的情况下,需要更温和的方法,例如我们实验室开发的方法。
此外,从田间生长的M植物中分离的纤维通过提高的生物力学参数(杨氏模量,强度)来表征(Wrobel-Kwiatkowska等,2009 )。在结构上,PHB-纤维素纤维不同于对照植物和过量生产苯丙烷化合物(亚麻称为W92)的植物,其先前用于制备伤口敷料。第一个在聚合物复合物中显示出更多的分子内和分子间氢键,表明其更高的晶体结构。分子内氢键为纤维素提供显着的硬度分子。IR研究的结果得出结论,转基因W92纤维的纤维素基质不如M纤维的结构紧密,其中纤维素聚合物的纤维更紧密地结合(Szopa等人,2009 )。所述生物聚合物复杂的布置可以通过影响木质素和果胶。化学和光谱分析证实,来自转基因M和对照植物的纤维之间在这些组分中没有主要差异。然而,已经检测到纤维素含量和排列的差异。强烈建议使用更高水平的纤维素聚合物和更高数量的分子内和分子间氢键,以及因此来自M植物的纤维中的聚合物结晶度,但目前难以推测该参数是否可影响伤口愈合。
慢性伤口处理过程中的一个重要问题是感染致病细菌和真菌,这些都与患者的发病率,并有助于增加医疗费用。M亚麻织物抑制病原微生物的生长,并且它比对照和棉织物更有效。微生物生长的抑制对于针对原发性或继发性感染的伤口保护是重要的,尤其是在慢性溃疡的情况下。通常,感染是由抗生素抗性细菌和真菌菌株引起的因此需要克服感染的新方法。亚麻织物的抗微生物活性源于多种因素的混合物,生物聚合物的结构和组成以及与聚合物结合的苯丙烷类含量。酚类具有抗微生物特性(Cava-Roda等,2012,Stojkovic等,2013)。特别是,发现阿魏酸抑制细菌和真菌生长(Cushnie和Lamb,2005,Papadopoulou等,2005,Pereira等,2007)。此外,发现存在于亚麻纤维中的CBD可能参与其抗菌活性(Appendino等,2008))。然而,到目前为止,亚麻纤维的抗微生物性质尚未在分子水平上得到充分认识。据推测,它是亚麻纤维中发现的许多成分的组合作用,如酚类,萜类,糖类和脂肪酸(Cowan,1999)。
总之,基于亚麻植物生产PHB的未加工织物对于伤口敷料非常有效,可能用于治疗慢性皮肤溃疡。温和的抗菌和抗真菌活性可能有助于防止在愈合过程中的任何污染。此外,由于这些纤维植物产生大量纤维(与先前使用的亚麻籽纤维相比),伤口处理的成本相当低,这在长期治疗慢性伤口的情况下尤其重要。
致谢
这项工作得到了弗罗茨瓦夫研究中心EIT +在"生物技术和先进医疗技术"项目的支持下- BioMed(POIG.01.01.02-02-003 / 08),由欧洲区域发展基金(运营计划创新经济,1.1)共同资助.2)和授予号码。178676从国家中心的研究和发展(NCBiR) ,波兰和2012/06 / A / NZ1 / 00006从国家科学中心(NCN,波兰)。